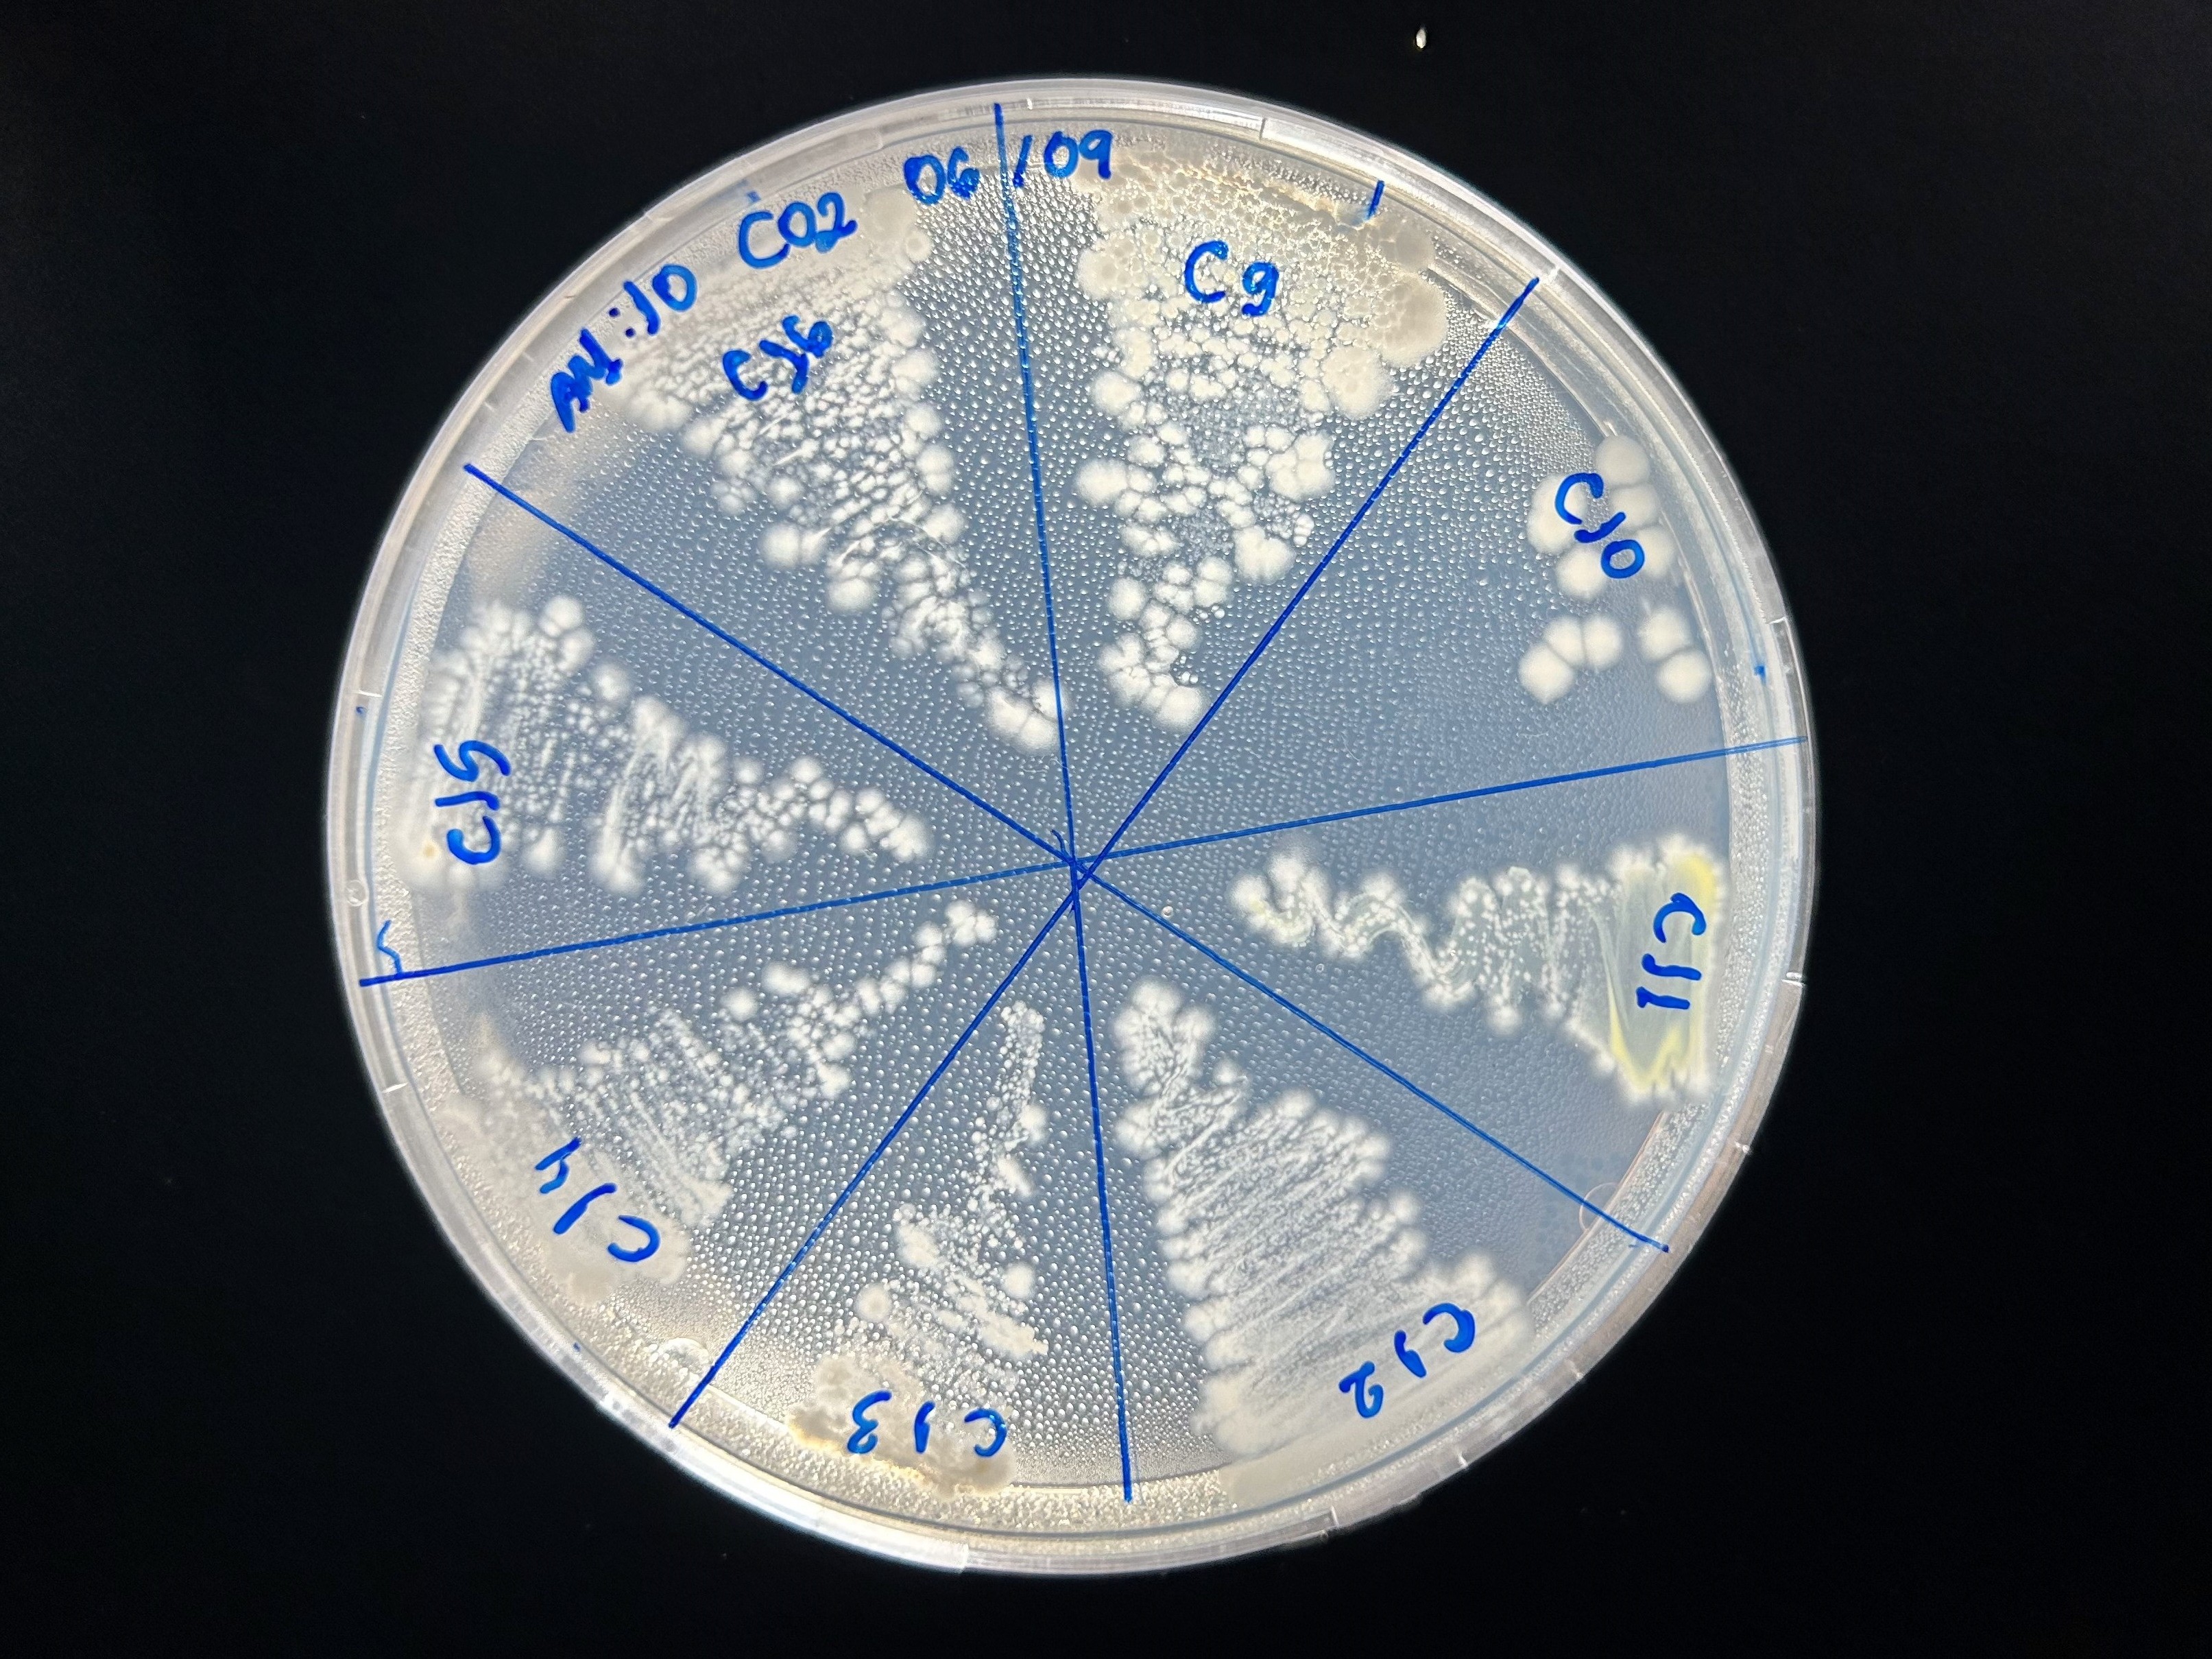
mais experimento com bactérias

What do we do?
Our research group works on the development of biostimulants and enhanced-efficiency fertilizers, focusing on innovative solutions that meet the growing demands of Brazilian agriculture. We seek alternatives that contribute to sustainability, reduce environmental impacts, and improve crop productivity under different growing conditions, particularly in the face of climate change. Much of our effort is directed at overcoming the limitations of urea use, which, despite being the main nitrogen source worldwide, shows nitrogen loss rates above 50% due to ammonia volatilization. This phenomenon not only reduces the economic efficiency of the fertilizer but also indirectly contributes to the formation of greenhouse gases, bringing environmental consequences. To address this challenge, we are developing new urease inhibitors tailored to Brazilian soils, particularly those in highly acidic regions and semi-arid areas (with water scarcity), as well as innovative biostimulants that enhance nutrient uptake, stimulate root growth, and increase plants’ ability to cope with water, heat, or nutrient stress, among others. Our goal is to develop more effective, affordable, and sustainable agricultural inputs, aligned with the guidelines of the National Fertilizer Plan 2050.
Enhanced-Efficiency Fertilizers
Our work covers a set of interconnected stages for the development of more effective formulations. These include the synthesis and isolation of substances, followed by tests in different soil types, such as those of the semi-arid region of Minas Gerais and the Cerrado. In parallel, we conduct molecular and biochemical studies to understand the mechanisms of action of the investigated substances. Based on these results, we seek to formulate products that are not only efficient but also safe, regulated, and easy to apply. Subsequent stages involve testing under controlled and field conditions, allowing us to assess the performance of the substances in real scenarios of Brazilian agriculture. In addition, we conduct careful analyses of toxicity, phytotoxicity, and environmental impact, ensuring that the proposed formulations preserve soil microbiota integrity and contribute to sustainable agricultural practices.

Biostimulants
Biostimulants have become established as strategic tools for the future of agriculture. When applied to seeds, plants, or directly to the soil, they activate natural processes that enhance nutrient uptake, increase plant metabolic efficiency, improve crop quality, and confer greater tolerance to abiotic stresses such as drought and high temperatures. Our group conducts rigorous research to identify substances with biostimulant potential, testing their effectiveness in different systems ranging from hydroponic cultivation to soil-based cultivation, which is closer to real field conditions. These experiments involve analyses of root growth, shoot development, nutrient uptake, and final plant yield. By integrating cutting-edge scientific knowledge with agricultural practice, we aim to create solutions capable of transforming the productivity and sustainability of the national agricultural sector.

